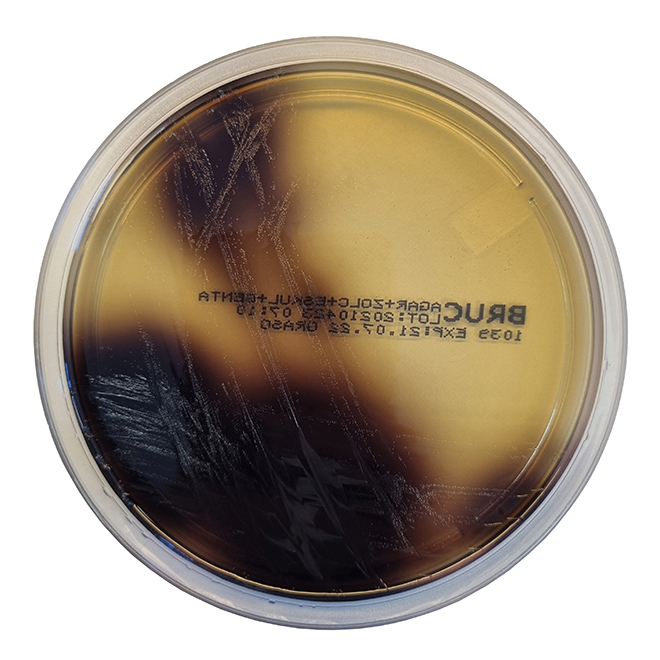

Über das Produkt
Fertigplatten zur Detektion und vorläufigen Identifikation von Bacteroides fragilis aus klinischen Proben und anderem Probenmaterial.
Galle-Aesculin-Gentamycin-Agar, Fertigplatten
Fertigplatten zur Detektion und vorläufigen Identifikation von Bacteroides fragilis aus klinischen Proben und anderem Probenmaterial.